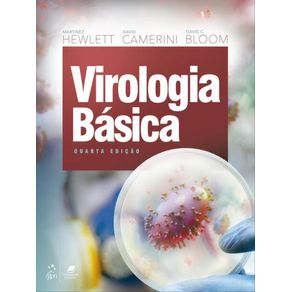
1059991.jpg 1059991.jpg

De: R$ 0,00Por: R$ 394,00ou X de
Calcule o frete:
Para envios internacionais, simule o frete no carrinho de compras.
Calcule o valor do frete e prazo de entrega para a sua região
Sinopse
Ficha Técnica
Especificações
| ISBN | 9788527739597 |
|---|---|
| Pré venda | Não |
| Peso | 1160g |
| Autor para link | HEWLETT MARTINEZ,CAMERINI DAVID,BLOOM DAVID C. |
| Livro disponível - pronta entrega | Sim |
| Dimensões | 1.8 x 21 x 28 |
| Idioma | Português |
| Tipo item | Livro Nacional |
| Número de páginas | 432 |
| Número da edição | 4ª EDIÇÃO - 2023 |
| Código Interno | 1059991 |
| Código de barras | 9788527739597 |
| Acabamento | BROCHURA |
| Autor | HEWLETT, MARTINEZ | CAMERINI, DAVID | BLOOM, DAVID C. |
| Editora | GUANABARA KOOGAN * |
| Sob encomenda | Não |